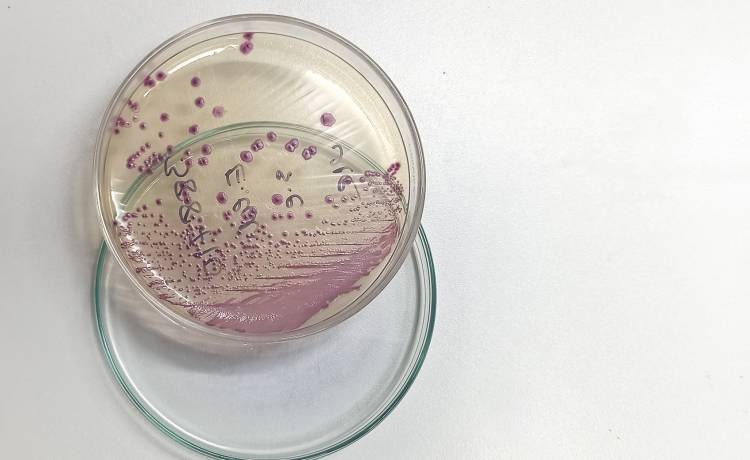
Zakaz kąpieli w kąpielisku w Gdańsku. Wykryto bakterię E. Coli

Bakterie E. coli w kąpielisku
Sezon letni rozpoczyna się pełną parą. Na 24 czerwca przypada również zakończenie roku szkolnego, przez co miejskie baseny i kąpieliska cieszyć się będą rosnącym zainteresowaniem. W Gdańsku otwarte miały zostać dwa kąpieliska – na Stogach i w Brzeźnie. Niestety finalnie otworzono tylko to drugie. Sanepid, który pobrał próbki wody z obu kąpielisk, wykrył w tych z kąpieliska w Stogach bakterie Escherichia coli, co uniemożliwiło planowane otwarcie. Ratownicy kategorycznie odradzają wchodzenie do wody w tym miejscu – kąpiel jest tam zakazana do odwołania.
Dlaczego E. coli jest niebezpieczna?
Bakteria Escherichia coli należy do grupy bakterii, które mogą zakazić nasz organizm i spowodować poważne problemy ze zdrowiem. Może przeniknąć do organizmu chociażby przez zainfekowaną wodę – bakteria ta ginie dopiero w temperaturze powyżej 60 stopni Celsjusza. W związku z tym zagotowanie wody w czajniku skutecznie uchroni nas przed zakażeniem się E. coli z tego źródła. Ale w miejscu takim jak gdańskie kąpielisko zagotowanie wody jest niemożliwe. Zakażenie się bakterią Escherichia coli wywołuje następujące objawy:
- Wymioty
- Biegunkę
- Skurczowe bóle brzucha
- Gorączka i ból głowy
Co więcej, bakteria E. coli może spowodować zapalenie dróg moczowych, opon mózgowych, a nawet sepsę. Ważne więc, aby nie leczyć się na własną rękę. W przypadku objawów, które utrzymują się przez 3 dni, warto udać się do lekarza. Należy również monitorować poziom wody w organizmie – kombinacja wymiotów i biegunki bardzo szybko odwadnia.